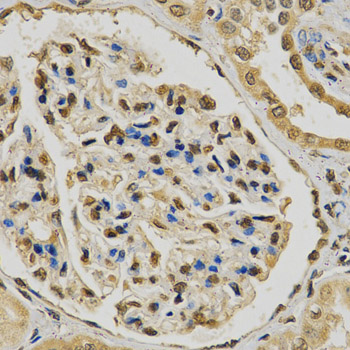

For quotations, please use our online quotation form, and you may also contact us by
service@kendallscientific.com
+1-888.733.6849 (Toll-free)
+1-617.299.7367 (Int’l))
+1-888.733.6849
Our customer service representatives are available 24 hours, Monday through Friday to assist you.| Reactivity | Human Mouse Rat |
| Tested applications | WB IHC IF |
| Recommended Dilution | WB 1:500 - 1:2000 IHC 1:50 - 1:200 IF 1:50 - 1:200 |
| Calculated MW | 46kDa |
| Observed MW | Refer to Figures |
| Immunogen | Recombinant protein of human EGLN1 |
| Storage Buffer | Store at -20℃. Avoid freeze / thaw cycles. Buffer: PBS with 0.02% sodium azide, 50% glycerol, pH7.3. |
| Concentration | f |
| Synonym | EGLN1;C1orf12;DKFZp761F179;ECYT3;HIFPH2;HPH2;PHD2;SM-20;SM20;ZMYND6 ; |

Western blot analysis of extracts of various cell lines, using EGLN1 antibody.
Immunohistochemistry of paraffin-embedded human kidney using EGLN1 antibody at dilution of 1:200 (x400 lens)

Immunofluorescence analysis of MCF-7 cell using EGLN1 antibody. Blue: DAPI for nuclear staining.

Immunofluorescence analysis of MCF-7 cell using EGLN1 antibody. Blue: DAPI for nuclear staining.
PHD1 (Egln2), PHD-2 (Egln1), and PHD3 (Egln3) are members of the Egln family of proline hydroxylases. They function as oxygen sensors that catalyze the hydroxylation of HIF on prolines 564 and 402, initiating the first step of HIF degradation through the VHL/ubiquitin pathway (1,2). PHD1 is highly expressed in a wide array of tissues whereas PHD2 and PHD3 are expressed mainly in heart and skeletal muscle (1,3). The mRNA levels of PHD are upregulated by HIF through the hypoxia-response element under low oxygen conditions (4-7). These three enzymes also exhibit different peptide specificity target proteins, PHD1 and PHD2 can hydroxylate both proline 402 and proline 564, but PHD3 can only hydroxylate proline 564 (2,8). In addition to HIF, PHD enzymes have also has been shown to catalyze the hydroxylation of RNA polymerase subunits and myogenin (3,9).
N/A